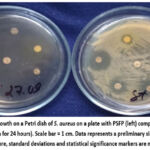
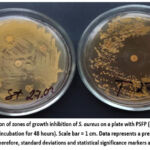

Manuscript accepted on :11-03-2026
Published online on: 18-03-2026
Plagiarism Check: Yes
Reviewed by: Dr. Putu Indah
Second Review by: Dr. Fariha Jasin Mansur
Final Approval by: Dr. Anton R Keslav
Oksana Barna1
, Nataliia Aponchuk1
, Lidiya Romanyuk2
, Mariia Hrabovets2
, Mariana Fedorovska3
and Mariia Shanaida4*
1Department of Pharmacy Management, Economics and Technology, I. Horbachevsky Ternopil National Medical University, Ternopil, Ukraine
2Department of Microbiology, Virology and Immunology , I. Horbachevsky Ternopil National Medical University, Ternopil, Ukraine.
3Department of Pharmacy and Pharmacology, Lesya Ukrainka Volyn National University, Lutsk
4Department of Pharmacognosy and Medical Botany, I. Horbachevsky Ternopil National Medical University, Ternopil, Ukraine
Corresponding Author E-mail: shanayda@tdmu.edu.ua
DOI : https://dx.doi.org/10.13005/bpj/3388
Abstract
Antibiotic resistance in many pathogenic microorganisms has become a serious challenge for medical doctors and scientists. Therefore, researchers are seeking effective natural remedies to address this problem. The research aimed to investigate the influence of technological factors on the selection of the optimal method of extracting bioactive compounds from the Blackthorn (Prunus spinosa L.) fruits and study the antimicrobial activity of the resulting phytosubstance (PSFP). Using the mathematical planning method gave us the possibility to choose the optimal extraction conditions, i.e., factor A: extraction method (a1 – maceration, a2 – maceration with stirring, a3 – re-maceration); factor B: type of extractant (b1 – 40% ethanol, b2 – 55% ethanol, b3 – 70% ethanol); factor C: plant raw material (PRM) to extractant ratio (c1 – 1:5, c2 – 1:10, c3 – 1:15). It was established that the most effective extraction of bioactive compounds occurred using the maceration with stirring method, 40% ethanol as the extractant, and 1:5 as the PRM to extractant ratio. The obtained PSFP was characterized as containing 2.43% flavonoids and 0.03% anthocyanins. During the study of antimicrobial activity of the developed PSFP, it was established that it exhibited a complex antimicrobial effect that extends beyond simple toxicity and exerts a bacteriostatic impact on Staphylococcus aureus. It was found that the antimicrobial effect of the PSFP against S. aureus depends on its concentration. With the simultaneous use of the PSFP and antibiotics such as cephalosporins and chloramphenicol, an increase in their action in vitro was noted, due to the ability of polyphenolic compounds to act as efflux pump inhibitors in Staphylococci. It may contribute to enhancing the activity of selected antibiotics in vitro, warranting further mechanistic and pharmacological investigation.
Keywords
Antimicrobial effect; Blackthorn fruits; Phenolic compounds; Spectrophotometric analysis; Staphylococcus aureus; Technological factors; Various extraction conditions
Download this article as:| Copy the following to cite this article: Barna O, Aponchuk N, Romanyuk L, Hrabovets M, Fedorovska M, Shanaida M. Optimal Method Selection for Extracting Bioactive Compounds from Prunus spinosa L. Fruits and Evaluating the Antimicrobial Activity of the Resulting Extract. Biomed Pharmacol J 2026;19(1). |
| Copy the following to cite this URL: Barna O, Aponchuk N, Romanyuk L, Hrabovets M, Fedorovska M, Shanaida M. Optimal Method Selection for Extracting Bioactive Compounds from Prunus spinosa L. Fruits and Evaluating the Antimicrobial Activity of the Resulting Extract. Biomed Pharmacol J 2026;19(1). Available from: https://bit.ly/4uy6wR2 |
Introduction
One of the fundamental historical inventions in medicine is the discovery of antibiotics – drugs that have a destructive effect on microorganisms that are responsible for numerous infectious diseases. Their use facilitated the treatment of almost all bacterial infectious diseases and increased the general welfare of the world population. According to a large-scale study published in The Lancet in 2024, improving access to appropriate antibiotics for treating infectious diseases could save about 92 million lives between 2025 and 2050. Today, there is a growing demand for the discovery of new antimicrobial agents due to the decrease in their effectiveness.1 They can improve the effectiveness of antibiotics that have been created and used so far.
Antibiotic resistance in many pathogenic microorganisms has become a serious challenge for medical professionals and researchers.2 Antibiotic resistance is a natural phenomenon that can render all known antibiotics ineffective in combating bacterial infections. This issue has prompted scientists to search for effective agents to combat it using biologically active substances of natural origin.2-4
Blackthorn (Prunus spinosa L.) fruits have long been studied by scientists in the field of pharmacy and medicine as a source of compounds with antioxidant, anti-inflammatory and antimicrobial activity. Since Blackthorn is unpretentious to growing conditions, it tolerates drought and frost and can grow on different soil types, it is widely distributed throughout the world. This makes it commonly available for the harvesting of plant raw materials. According to scientific data, Blackthorn fruits are used to compound or prepare medicines for external application with antibacterial and reparative effects.5
The fruits of Prunus spinosa are traditionally used in folk medicine and nutrition due to their valuable bioactive compounds.6 Blackthorn fruits have attracted considerable attention as functional raw materials and an undervalued source of bioactive compounds useful for application in the pharmaceutical and food industries. The pharmacological efficacy of Prunus spinosa fruits is directly correlated with their high content of biologically active substances. The main classes of compounds found in the fruits include pectic substances, various phenolic compounds, organic acids, triterpenes and vitamins.6-9 However, despite the documented phytochemical profile of blackthorn fruits, there is a clear research gap regarding the targeted antimicrobial activity of these compounds against Staphylococcus aureus. Given the increasing antibiotic resistance of this pathogen, addressing this gap is crucial for evaluating Prunus spinosa as a potential source of natural antistaphylococcal agents.
The phytochemicals contained in Blackthorn fruits affect the bacterial cell membranes, disrupting their integrity and corresponding to innovative strategies to combat resistant strains. However, the literature data on the antimicrobial properties of Blackthorn fruits are contradictory. Authors from Ovidius University of Constanta (Romania) studied the antibacterial and antifungal effects of Blackthorn fruit aqueous extracts. They found that the extracts did not have antifungal activity, but strains of the bacteria Staphylococcus aureus and Escherichia coli were sensitive to them.10
Romanian researchers who studied Blackthorn leaves found that their aqueous and ethanolic extracts had significant antibacterial effects, in particular against Bacillus cereus and Enterobacter cloacae. Gabriela Mitea et al. experimentally demonstrated that various plant parts (fruits, leaves, flowers) contain flavonoids, phenolic acids and anthocyanins, which provide them with significant antioxidant, antibacterial and anti-inflammatory properties. 11
Staphylococcus aureus is an extremely common microorganism that is a representative of the normal microbiota of many human biotopes and, under certain circumstances, is capable of causing a wide range of communicable diseases, starting with postoperative wound suppuration, boils, carbuncles, upper respiratory tract diseases, complications of numerous viral infections and ending with sepsis.12
The article aimed to investigate the influence of technological factors on the extraction efficiency of biologically active substances (BAS) from Blackthorn (Prunus spinosa) fruits and to evaluate the antimicrobial activity of the obtained phytosubstance (PSFP) against the gram-positive microorganism Staphylococcus aureus.
Materials And Methods
Plant raw materials (PRM). The Blackthorn fruits, fully ripe of black colour, were harvested during autumn in the Ternopil region of Ukraine. The fruits, dried in air and crushed using a laboratory grinder, were studied according to the methods described in the European Pharmacopoeia.13
Obtaining phytosubstances
Three extraction methods were used to obtain phytosubstances. In each method, three extractants were used: 40%, 55%, 70% ethanol. The extractants were poured into the PRM in different ratios (1:5, 1:10, 1:15).14-16
When applying the maceration method, the PRM were poured with the extractant and infused for seven days at room temperature. The resulting extract was drained, and the processed raw materials were washed with a small portion of the extractant, both parts of the extract were combined.17, 18 When applying the maceration method with stirring, the PRM was poured with the extractant, followed by infusing for seven days, stirring occasionally. The ready extract was obtained as described above.18
During the re-maceration process, the PRM was mixed with 1/3 of the extractant volume and left to infuse for one day. This step was repeated twice and all 3 parts of the extract were combined, according to the methodology described previously.19
The developed extracts were purified through two steps: сold precipitation – the extracts were incubated in a refrigerator at 2-8 °C for 48 h until clear liquids were obtained; filtration – the clarified liquids were filtered through a paper filter. The purified liquid extracts were evaporated in vacuum evaporator at 60 °C to a thick mass with constant weight – the primary samples of the Prunus spinosa fruit phytosubstance (PSFP) were obtained.
Study of the dry residue
To determine the dry residue, 5.0 mL of the liquid extract was placed in a weighed flat-bottomed dish, evaporated on a water bath and dried at a temperature of 100 °C to 105 °C for 3 hours. The flat-bottomed dish was cooled over diphosphorus pentoxide in a desiccator at room temperature for 30 min and weighed.13
Spectrophotometric analysis
The solvents and reagents were purchased from the company “Sfera Sim” (Lviv, Ukraine), and standard pharmacopoeial samples were purchased from the State Enterprise “Pharmacopoeial Center” in Kharkiv, Ukraine. A ULAB 108 UV spectrophotometer was utilized to determine the total contents of flavonoids and anthocyanins.
The quantitative analysis of total flavonoid content was conducted using appropriate methodologies.13, 20-23 0.1 g (exact weight) of the phytosubstance was mixed with 96 % ethanol R to 25 mL in a volumetric flask (solution A). 2 mL of the resulting solution A, 1 mL of 2% alcoholic solution of aluminium chloride were mixed with 96% ethanol R to 25 mL in a volumetric flask (solution B). Solution B was kept for 40 minutes and the optical density was measured on the spectrophotometer at a wavelength of 410±2 nm. A reference solution was utilized: 2 mL of solution A, 1-2 drops of acetic acid were mixed with 96% ethanol R to 25 mL in a volumetric flask.
The analysis of total anthocyanin content was as follows: 0.10 g (exact weight) of the phytosubstance was mixed with methanol R to 25 mL in a volumetric flask, dissolved by shaking for 15 min, and the obtained solution was filtered. The optical density was measured at a wavelength of 528±2 nm, using a 0.1% solution of hydrochloric acid R in methanol R as a compensation solution.13, 24
All experiments were conducted in triplicate.
Method of mathematical planning
The method of mathematical planning the obtaining of reliable research results while preserving the analysis of experimental data and reducing the time and number of research trials. To plan the experiment, we used the third-generation Graeco-Latin square which is a method of variance analysis that allows to reduce the number of trials from 81 to 9 in a full factorial study. At the same time, we obtain the relevant data about the influence of each studied parameter on the extraction efficiency of active compounds from the Blackthorn fruit.25-27
The antimicrobial activity determination.
The study was conducted with an extract that had been previously evaporated to a thick mass with a constant weight. To eliminate the influence of ethanol on bacterial cells and demonstrate the PSFP antimicrobial effect, it was dissolved in a sodium chloride solution (9 mg/mL) such that 1 mL of solution contained 100 mg of the PSFP.
The antimicrobial activity determination was performed analogously to the standardized method of serial dilutions in a liquid medium28, by multiple dilution of the resulting solution in peptide meat broth (PMB) and adding a bacterial suspension of 106 CFU/ML (S. aureus) to each tube (Table 1).29
Table 1: Schematic representation of the antimicrobial activity determination of the developed PSFP by the serial dilution method
| Components, mL | Test tubes | |||||||||
| 1 | 2 | 3 | 4 | 5 | 6 | 7 | 8 | Bacteria control | Control of the phytosubstance | |
| PMB | 5.0 | 5.0 | 5.0 | 5.0 | 5.0 | 5.0 | 5.0 | 5.0 | 5.0 | 5.0 |
| PSFP 100 mg/mL | 5.0 | → | → | → | → | → | → | ↑ | – | 5.0 |
| Concentration mg/mL | 50 | 25 | 12.5 | 6.3 | 3.2 | 1.6 | 0.8 | 0.4 | 50 | |
| Bacterial suspension 106 CFU/mL | 1.0 | 1.0 | 1.0 | 1.0 | 1.0 | 1.0 | 1.0 | 1.0 | 1.0 | – |
The potential enhancement of antibiotic activity effect of antimicrobial drugs and the PSFP was studied by the disk-diffusion method according to the requirements of the Order of the Ministry of Health of Ukraine No. 1513 (dated August 23, 2023). Standard paper discs with antibiotics, manufactured by Pharmaktiv LLC (Ukraine), were used. The antibiotics were purchased in the local pharmacies in Ternopil (Ukraine). The study was conducted once, and result interpretation (inhibition zone diameters) was carried out according to the threshold values determined by EUCAST (version 14.0, 2024).
Results
To obtain the PSFP, three factors were studied, namely: extraction method, ratio of PRM to extractant, type of extractant (Table 2). Each of the abovementioned factors was studied at three levels. It was found that for effective extraction of active compounds, it is appropriate to choose long-term contact extraction, namely: maceration, maceration with stirring and re-maceration.14-15, 17-19
Table 2: The technological factors studied during the conducted extraction
| Factors | Factor levels |
| А – extraction method | а1 – macerationа2 – maceration with stirring
а3 – re-maceration |
| В – type of extractant | в1 – 40 % ethanolв2 – 55 % ethanol
в3 – 70 % ethanol |
| С – PRM to extractant ratio | с1 – 1:5с2 – 1:10
с3 – 1:15 |
According to the selected factors and factor levels, a three-factor experiment planning matrix based on a 3×3 Greco-Latin square was selected, which is shown in Table 3.
Table 3: Planning matrix for the three-factor experiment based on the 3×3 Greco-Latin square: the influence of technological factors on the extraction efficiency of BAS from the Prunus spinosa fruits
| № | А | В | С | y1 | y2 | y3 |
| 1 | a1 | в1 | с1 | 4.330 | 1.550 | 0.094 |
| 2 | a1 | в2 | с2 | 2.930 | 1.677 | 0.007 |
| 3 | a1 | в3 | с3 | 2.040 | 1.648 | 0.006 |
| 4 | а2 | в1 | с2 | 3.520 | 3.246 | 0.003 |
| 5 | а2 | в2 | с3 | 2.120 | 1.547 | 0.007 |
| 6 | а2 | в3 | с1 | 4.140 | 1.615 | 0.028 |
| 7 | а3 | в1 | с3 | 1.820 | 2.608 | 0.009 |
| 8 | a3 | в2 | с1 | 2.620 | 4.888 | 0.006 |
| 9 | а3 | в3 | с2 | 3.120 | 0.192 | 0.017 |
| Note:y1 – dry residue, %;
y2 – total content of flavonoids, %; у3 – total content of anthocyanins, %; |
||||||
The next studies for the obtained PSFPs were conducted regarding influence of technological factors on the BAS extraction, which were analysed using variance analysis and for which graphs were constructed. These graphs allowed us to observe the influence of extraction methods, type of extractant, PRM to extractant ratio, in order to select the best parameters for the PSFP obtaining.24
The influence of the extraction method (factor A) on the dry residue content in the liquid extract revealed that the maximum BAS yield (3.26%) was achieved via maceration with stirring. Standard maceration yielded 3.1%, while re-maceration produced 2.52%. Examination of factor B (type of extractant) showed that using 40% and 70% ethanol yielded practically the same amount of dry residue – 3.22% and 3.1%, respectively. The lowest yield of dry residue (2.56%) occurred with 55% ethanol.
Analysis of factor C (PRM to extractant ratio), demonstrated that the highest dry residue (3.70%) was obtained at a 1:5 ratio. Ratios of 1:10 and 1:15 yielded 3.19% and 2.0%, respectively (Fig. 1).
![]() |
Figure 1: The influence of PRM to extractant ratio on the dry residue content in the liquid extract of Prunus spinosafruits. |
The results from the investigation of technological factors on flavonoid extraction showed that factor B had the greatest impact. Flavonoid content reached 2.56% with re-maceration, 2.14% with maceration with stirring, and 1.63% with standard maceration.
When investigating factor B, it was established that the highest flavonoid content (2.70%) was extracted with 55% ethanol. The use of 40% ethanol yielded 2.47% flavonoids, while 70% ethanol yielded 1.15% (Fig.2).
![]() |
Figure 2: The influence of the type of extractant on the flavonoid yield from Prunus spinose fruits. |
The analysis of the PRM to extractant ratio showed that the maximum flavonoid yield (2.68%) was obtained at a 1:5 ratio. Ratios of 1:10 and 1:15 yielded nearly equivalent amounts of BAS, 1.70% and 1.94%, respectively.
The study of the extraction method (factor A) effect on anthocyanin yield from Prunus spinosa fruits showed that the maximum anthocyanin content (0.035%) was achieved using standard maceration. Maceration with stirring and re-maceration yielded approximately equivalent amounts of BAS, that is 0.013% and 0.011%, respectively. Investigation of factor B established that anthocyanin extraction was most effective with 40% ethanol, yielding 0.035%. With 70% ethanol, the yield of anthocyanins was 0.017%, and with 55% ethanol – 0.007% respectively.
Results for factor C demonstrated the following ranking: c1 > c2 > c3, as shown in Fig. 3.
![]() |
Figure 3: The influence of the PRM to extractant ratio on the anthocyanin yield from Prunus spinosa fruits. |
The highest anthocyanin content (0.042%) was observed at a 1:5 ratio. A 1:10 ratio yielded 0.009% anthocyanins, while a 1:15 ratio yielded 0.007%, respectively.
Experimental results demonstrated that optimal extraction of BAS from Prunus spinosa fruits – specifically dry residue, quantitative content of flavonoids and anthocyanins – was achieved using the following technological parameters:
Extraction methods – maceration with stirring and re-maceration;
Type of extractant – 40% ethanol;
PRM to extractant ratio – 1:5.
Given that the two investigated methods (maceration with stirring and re-maceration) showed nearly equivalent BAS yields, we proceeded to analyse the desirability function for these technological factors, as presented in Table 4.
Table 4: Summary of the desirability function by 3 responses
| № | y1 | d1 | y2 | d2 | y3 | d3 | D |
| 1 | 4.33 | 0.96 | 1.5498 | 0.73 | 0.0937 | 0.98 | 0.88 |
| 2 | 2.93 | 0.81 | 1.6769 | 0.75 | 0.0069 | 0.43 | 0.64 |
| 3 | 2.04 | 0.50 | 1.6480 | 0.74 | 0.0061 | 0.42 | 0.53 |
| 4 | 3.52 | 0.89 | 3.2464 | 0.91 | 0.0034 | 0.37 | 0.67 |
| 5 | 2.12 | 0.56 | 1.5496 | 0.72 | 0.0072 | 0.45 | 0.57 |
| 6 | 4.14 | 0.94 | 1.6155 | 0.74 | 0.0276 | 0.71 | 0.79 |
| 7 | 1.82 | 0.44 | 2.6080 | 0.88 | 0.0088 | 0.48 | 0.58 |
| 8 | 2.62 | 0.75 | 4.8878 | 0.98 | 0.0061 | 0.42 | 0.68 |
| 9 | 3.12 | 0.84 | 0.1920 | 0.39 | 0.0171 | 0.55 | 0.77 |
The desirability scale “d” is defined in the range from “0” to “1”. The value ‘0’ is a completely unacceptable level of this property, and the value “1” corresponds to the best value. To construct a generalized desirability function, the obtained values (y1, y2, y3) are converted to a dimensionless desirability scale (d1, d2, d3). The results obtained are subjected to variance analysis.25
Analysis of the desirability function for factor A revealed the following ranking: a1 > a2 > a3 (Fig. 4).
![]() |
Figure 4: Desirability function for the influence of the extraction method on BAS yield from Prunus spinosa fruits. |
The influence of the extraction method on the desirability function is shown in Figure 4, which indicates that the highest BAS yield (d=0.77) is achieved using maceration with stirring. Standard maceration yields d=0.72, while re-maceration yields d=0.53.
Figure 5 presents the results of the desirability function analysis for the influence of the type of extractant on BAS yield. The highest yield (d=0.77) is obtained with 40% ethanol. Using 55% and 70% ethanol yields slightly lower amounts, d=0.71 and d=0.54, respectively.
![]() |
Figure 5: Desirability function for the influence of the type of extractant on BAS yield from Prunus spinosa fruits. |
Analysis of the desirability function (Fig. 6) reveals that the highest BAS yield (d=0.81) was observed at the PRM to extractant ratio of 1:5, compared to d=0.7 at the 1:15 ratio and d=0.52 at the 1:10 ratio.
![]() |
Figure 6: Desirability function for the influence of the PRM to extractant ratio on BAS yield from Prunus spinosa fruits. |
After analysing the desirability function for the investigated parameters, the following technological factors were selected for obtaining the final sample of the PSFP:
Extraction method – maceration with stirring;
Type of extractant – 40% ethanol;
PRM to extractant ratio – 1:5.
These parameters were applied to obtain the PSFP, which is an orange-brown viscous mass (shown in Fig. 7) with a faint odour and sweet-astringent taste.
![]() |
Figure 7: The appearance of the developed PSFP. |
The subsequent studies of the PSFP included quantitative analysis of BAS: the total content of flavonoids was 2.43%, and the total content of anthocyanins was 0.03%.
On the next stage, the antimicrobial activity of the obtained PSFP was evaluated. After using the serial dilution method, the bacteriostatic effect against S. aureus ATCC 6538 at a concentration of 50 mg/mL was not observed (Fig. 8).
![]() |
Figure 8: Determination of antimicrobial activity of the PSFP, in relation to the strain S. aureus ATCC 6538, by the method of serial dilutions in liquid medium |
However, we were interested in the possibility of additive-like effect mediated effect of the active compounds of the PSFP on microorganisms, due to the inhibition of efflux pumps, which play a crucial role in the removal of antibacterial agents from the microbial cells. Efflux pumps (Multidrug Efflux Systems, MES) are membrane transport proteins that actively pump antimicrobial agents (including antibiotics) out of the cell, thereby reducing their effective intracellular concentration. George P. Tegos et al.30 have shown that tannic acid, as well as other polyphenols, can act as the efflux pump inhibitor. In particular, they can inhibit the NorA pump in Staphylococcus aureus. Inhibition of these pumps allows for an increase in the accumulation of antimicrobial substances in the bacterial cytoplasm. I. Inhibition of these pumps allows to increase the accumulation of antimicrobial substances in the bacterial cytoplasm. Some polyphenols, acting as efflux pump inhibitors, can restore bacterial susceptibility to classical antibiotics, making them effective even at sub-minimum inhibitory concentrations. Thus, polyphenols from Prunus spinosa fruits not only as direct antimicrobial agents but also as synergists that can overcome drug excretion-mediated resistance (resistance mediated by drug excretion). It is important to emphasize that these mechanisms are hypothetical and inferred from the broader literature on the biological activities of polyphenols.
Our experimental research supposed the additive-like effect of the chosen antibiotics and the PSFP on S. aureus ATCC 6538. When adding to the Muller-Hinton agar the PSFP in a quantity of 100 mg/mL and then inoculating it with a suspension of S. aureus and placing on the dried inoculation of disks with antibiotics, after 24 hours of incubation in a thermostat at a temperature of 37º C, there was no microbial growth on the experimental Petri. At a concentration of 100 mg/mL, a pronounced bacteriostatic effect was observed in the agar diffusion model. (Fig. 9).
![]() |
Figure 9: Lack of growth on a Petri dish of S. aureus on a plate with PSFP (left) compared to the control (right) (incubation for 24 hours). Scale bar = 1 cm. Data represents a preliminary single-run screening (n=1); therefore, standard deviations and statistical significance markers are not applicable. |
![]() |
Figure 10: Formation of zones of growth inhibition of S. aureus on a plate with PSFP (right) compared to the control (left) (incubation for 48 hours). Scale bar = 1 cm. Data represents a preliminary single-run screening (n=1); therefore, standard deviations and statistical significance markers are not applicable. |
After incubation for 48 hours on the Petri dish with added to the medium the PSFP, we observed the appearance of single colonies of S. aureus and formation of growth arrest zones around the discs in comparison with the confluent growth on the control dish (Fig.10). It was also found the clearly visible diameters of the growth inhibition zones around the disks with three antibiotics in contrast to the control where only two zones of the much smaller diameters were outlined, which indicates the additive-like effect of certain antibiotics with the PSFP and its bacteriostatic effect on gram-positive microorganisms (Table 5).
Table 5: Antimicrobial activity of the PSFP in combination with antimicrobial drugs (disc diffusion method).
| Antimicrobial discs | Mueller-Hinton agar | Mueller-Hinton agar +PSFP |
| Azithromycin15 mcg/disk | R (absence of growth inhibition zone) | R (absence of growth inhibition zone) |
| Erythromycin15 mcg/disk | R (absence of growth inhibition zone) | R (absence of growth inhibition zone) |
| Cefotaxime30 mcg/disk | 20 mm | 34 mm |
| Chloramphenicol 30 mcg/disk | 18 mm | 22 mm |
| Amoxicillin20 mcg/disk | R (absence of growth inhibition zone) | R (absence of growth inhibition zone) |
| Ceftriaxone30 mcg/disk | 10 mm | 20 mm |
This microbiological evaluation was designed as a preliminary screening to establish baseline activity. The tests were performed as single-run exploratory experiments. The assessment of growth retardation zones was carried out according to the threshold values determined by EUCAST (version 14.0, 2024)
As can be seen from the table, the PSFP enhances the effect of third-generation cephalosporins (ceftriaxone, cefotaxime) and slightly of chloramphenicol, but does not affect resistance to macrolides (azithromycin and erythromycin) and semi-synthetic penicillins.
Discussion
It could be regarded that the overall antimicrobial activity of Prunus spinosa fruit extracts is the result of the complex additive-like effect of their active compounds.30,31 According to various authors, the antimicrobial activity is strongly correlated with the content of polyphenols in the extract. To obtain extracts rich in polyphenols, the choice of a polar solvent was critical. The studies showed that 80% is the most effective for the extraction of total polyphenol content, and strong antibacterial effects correlate precisely with extracts obtained with polar solvents such as ethanol.31 Therefore, it can be stated that the effect of the phytosubstance studied by us on microorganisms is multi-vector (Fig.11). This scheme illustrates the potential pathways of antibacterial action based on an extensive literature review. While our study confirms the high inhibitory efficacy of PSFP against S. aureus, the specific molecular mechanisms shown (e.g., efflux pump inhibition or iron chelating) remain hypothetical for this extract and require further experimental validation.
![]() |
Figure 11: Proposed antimicrobial mechanisms and hypothetical pathways of the antibacterial action of P. spinosa polyphenols (based on literature data). |
This multi-pronged attack on vital processes (metabolism, membrane integrity, and genetic replication) significantly reduces the probability of bacterial resistance to natural polyphenols like tannins compared to antibiotics, which usually have a single molecular target. There is information in the literature about the antimicrobial effect of Blackthorn fruit ethanol extracts on both gram-positive and gram-negative microorganisms, as well as on fungi of the Candida genus.7, 31
The presence of various classes of polyphenolic compounds is a key characteristic of Prunus spinosa fruits. Analysis of the polyphenolic composition revealed a total of 27 phenolic compounds, primarily consisting of hydroxybenzoic acid derivatives, hydroxycinnamic acid derivatives, flavonoids, and anthocyanins, in the fruits collected from central Serbia.6 The latter method was considered optimal because the extract obtained from it demonstrated the highest content of polyphenols and the best level of antioxidant activity.32
The ethanol extract from the blackthorn fruits that was rich in polyphenols demonstrated significant antimicrobial activity against Staphylococcus aureus ATCC 6538, Pseudomonas aeruginosa ATCC 9027, Escherichia coli ATCC 8739, and Salmonella abony NCTC 6017.33
Several varieties of Prunus domestica cultivated in Ukraine were studied regarding the composition of phenolic compounds in the presscake of fruits using chromatographic and spectrophotometric methods.34 Ten phenolic compounds were identified using the HPLC method: three flavonoids, five hydroxycinnamic acids, and two phenolic acids. The antimicrobial activity of the 50 % alcohol extract from plum presscake was investigated using the agar diffusion method. The extract demonstrated the highest activity against gram-positive microorganisms (Staphylococcus aureus, Bacillus subtilis) with inhibition zones measuring 20–21 mm. The results indicated the significant potential for complex processing of the studied raw materials, which could lead to the development of new antimicrobial drugs.
Magiera et al.35 studied the phytochemical composition of fresh Prunus spinosa fruits, and the fractional extraction method was used. Using the UHPLC method, fifty-seven phenolic components were identified. The total polyphenol content was up to 126.5 mg gallic acid equivalents/g dry weight. Polyphenolic polysaccharide-protein complexes were isolated from blackthorn fruits using both cold and hot water extraction methods.36
The study of blackthorn fruit from Romania identified optimal conditions for the ultrasonic extraction of polyphenols.37 Six process factors were investigated, including the ratio of solvent to plant material, the concentration of ethanol in the extraction solvent, extraction temperature, solvent pH, amplitude of the ultrasonic probe, and extraction time. To evaluate these factors, both a Plackett-Burman design and a central composite design were employed. The optimal settings revealed six phenolic compounds: rutin, protocatechuic acid, neochlorogenic acid, vanillic acid, chlorogenic acid and caffeic acid.
The ethanolic extract of Prunus spinosa fruits collected in southeastern Serbia showed significant antibacterial activity against some strains of ATCC Staphylococcus aureus, Escherichia coli, Pseudomonas aeruginosa and Salmonella abony NCTC 6017, with the exception of Bacillus subtilis. Moreover, the antifungal activity tested against two pathogenic fungi, such as Aspergillus niger and Candida albicans, was significant only against C. albicans. The antibacterial and bactericidal activity of the methanol extract of Prunus spinosa fruits was tested against gram-negative (E. coli, P. aeruginosa, Salmonella enteritidis, Shigella sonnei, Klebsiella pneumoniae and Proteus vulgaris) and gram-positive bacteria (Clostridium perfringens, B. subtilis, S aureus, Listeria innocua, Sarcina lutea and Micrococcus flavus), and in this study, the obtained results showed high antimicrobial activity of the extract against almost all tested bacterial strains, except Klebsiella pneumoniae. According to the available data, such bacteriostatic and bactericidal properties mainly depend on the presence of polyphenols. Therefore, studying the extraction efficiency of biologically active substances from Blackthorn fruits applying different parameters in order to obtain a phytosubstance with a high content of active compounds is essential.5,16
Study Limitations
It should be noted that the microbiological assays in the current work were conducted as an initial preliminary screening to identify potential antibacterial activity. Consequently, the assays were performed as single-run experiments, which limits the statistical power required for definitive conclusions regarding antimicrobial efficacy or true synergy. While these preliminary observations highlight the extract’s potential to enhance antibiotic activity, rigorous statistical validation (using technical and biological triplicates, mean ± SD) and specific synergy assays (such as checkerboard testing) are required in future comprehensive studies.
Conclusion
The application of mathematical planning methods enabled revealing key technological factors that influence the extraction efficacy to obtain PSFP: extraction method, type of extractant, and PRM to extractant ratio. The spectrophotometric analysis determined the total content of flavonoids (2.43%) and anthocyanins (0.03%). The optimal BAS yield from Prunus spinosa. fruits was achieved using maceration with stirring, 40% ethanol as extractant, and a 1:5 as PRM to extractant ratio.
The obtained PSFP demonstrated an antimicrobial effect that goes beyond simple toxicity and causes a bacteriostatic effect on Staphylococcus aureus, which is characterized by rapid acquired resistance to many antimicrobial drugs. Generally, the antimicrobial effect of this phytosubstance against Staphylococcus aureus depended on its concentration. With the simultaneous use of the PSFP and antibiotics such as cephalosporins and chloramphenicol, an increase in their action in vitro it was noted, which can be utilized to overcome antimicrobial resistance due to a possible additive-like effect.
Acknowledgment
The authors wish to thank the administration of I. Horbachevsky Ternopil National Medical University for their support of this research.
Funding Source
The author(s) received no financial support for the research, authorship, and/or publication of this article.
Conflict of Interest
The author(s) declare no conflict of interest.
Data Availability Statement
This statement does not apply to this article.
Ethics Statement
This research did not involve animal subjects, human participants, or any material that requires ethical approval.
Informed Consent Statement
This study did not involve human participants, and therefore, informed consent was not required.
Clinical Trial Registration
This research does not involve any clinical trials.
Permission to reproduce material from other sources
Not Applicable
Author Contributions
- Oksana Barna and Lidiya Romanyuk: Conceptualization, Methodology, Analyses, Writing – Original Draft.
- Nataliia Aponchuk and Mariia Hrabovets: Preparation of raw material samples for analysis; reference search, conducting analyses and interpretation of the obtained data.
- Mariana Fedorovska: Writing – review & editing.
- Mariia Shanaida: Writing the part of discussion section, reviewing & editing.
References
- Attard ST, Aldilla VR, Kuppusamy R, et al. Tuning the structure–functional properties within peptide-mimicking antimicrobial hydrogels. Antibiotics (Basel). 2025;14(11):1118. doi:10.3390/antibiotics14111118
CrossRef - Popa SL, Pop C, Dita MO, et al. Deep Learning and Antibiotic Resistance. Antibiotics (Basel). 2022;11(11):1674. Published 2022 Nov 21. doi:10.3390/antibiotics11111674
CrossRef - Guglielmi P, Pontecorvi V, Rotondi G. Natural compounds and extracts as novel antimicrobial agents. Expert Opin Ther Pat. 2020;30(12):949-962. doi:10.1080/13543776.2020.1853101
CrossRef - Shanaida M, Hudz N, Białoń M, et al. Chromatographic profiles and antimicrobial activity of the essential oils obtained from some species and cultivars of the Mentheaetribe (Lamiaceae). Saudi J Biol Sci. 2021;28(11):6145-6152. doi:10.1016/j.sjbs.2021.06.068
CrossRef - Nistor OV, Milea ȘA, Păcularu-Burada B, Andronoiu DG, Râpeanu G, Stănciuc N. Technologically Driven Approaches for the Integrative Use of Wild Blackthorn (Prunus spinosa) Fruits in Foods and Nutraceuticals. Antioxidants (Basel). 2023;12(8):1637. doi:10.3390/antiox12081637
CrossRef - Marčetić M, Samardžić S, Ilić T, Božić DD, Vidović B. Phenolic composition, antioxidant, anti-enzymatic, antimicrobial and prebiotic properties of Prunus spinosa fruits. Foods. 2022;11(20):3289. doi:10.3390/foods11203289
CrossRef - Klymniuk SI, Sytnyk IO, Shyrobokov VP. Praktychna mikrobiolohiia [Practical Microbiology]. Vinnytsia, Ukraine: Nova Knyha; 2018
- Mitea G, Schröder V, Iancu IM, Lupoae M, Dumitru CN, Radu MD. Prunus spinosa – source of bioactive compounds with antioxidant and pharmacological predicted activity. Pol J Environ Stud. 2025. doi:10.15244/pjoes/209837
CrossRef - Negrean OR, Farcas AC, Pop OL, Socaci SA. Blackthorn-A Valuable Source of Phenolic Antioxidants with Potential Health Benefits. Molecules. 2023;28(8):3456. doi:10.3390/molecules28083456
CrossRef - Gegiu G, Branza AD, Bucur L, Grigorian M, Tache T, Badea V. Contributions to the antimicrobial and antifungal study of the aqueous extract of Prunus spinosa Farmacia. 2015;63(2):275-279
- Veličković I, Žižak Ž, Rajčević N, et al. Prunus spinosa leaf extracts: polyphenol profile and bioactivities. Not Bot Horti Agrobot Cluj Napoca. 2021;49(1):12137. doi:10.15835/nbha49112137
CrossRef - Romanyuk L, Malinovska L, Kravets N, Olyinyk N, Volch I. Analysis of antibiotic resistance of conditionally pathogenic oropharyngeal microflora in children after viral respiratory infections. Georgian Med News. 2022;(328-329):154-157
- European Pharmacopoeia: XII edition. Council of Europe. 2025.
- Darotulmutmainnah Azmi, Marini Marini, Herliningsih Herlingsih, Handayani, Hana. Comparison of total flavonoid content and antioxidant activity of purple leaf extract (Graptophyllum pictum () GRIFF.) using maceration and soxhletation extraction methods. Medical Sains: Jurnal Ilmiah Kefarmasian 2025;1(10):27-34 DOI: 10.37874/ms.v10i1.1633
CrossRef - Naviglio D, Trifuoggi M, Varchetta F, Nebbioso V, Perrone A, Avolio L, De Martino E, Montesano D, Gallo M. Efficiency of Recovery of the Bioactive Principles of Plants by Comparison between Solid–Liquid Extraction in Mixture and Single-Vegetable Matrices via Maceration and RSLDE. 2023; 12(16):2900. https://doi.org/10.3390/plants12162900
CrossRef - Drăghici-Popa AM, Boscornea AC, Brezoiu AM, Tomas ȘT, Pârvulescu OC, Stan R. Effects of Extraction Process Factors on the Composition and Antioxidant Activity of Blackthorn (Prunus spinosa) Fruit Extracts. Antioxidants (Basel).2023;12(10):1897. doi:10.3390/antiox12101897
CrossRef - Chibuye Bitwell, Singh Sen Indra, Chimuka Luke, Maseka Kenneth Kakoma. A review of modern and conventional extraction techniques and their applications for extracting phytochemicals from plants. Scientific African.2023;19.e01585. https://doi.org/10.1016/j.sciaf.2023.e01585
CrossRef - Zulfa Ajrina Fitri, Farhad Ahmadi, M. Ashraful Islam, Eric N. Ponnampalam, Frank R. Dunshea, Hafiz A. R. Suleria. A Systematic Review of Extraction Methods, Phytochemicals, and Food Applications of Moringa oleifera Leaves Using PRISMA Methodology. Food Science & Nutrition, 2025; 13:e70138. https://doi.org/10.1002/fsn3.70138
CrossRef - Anthonin Gori, Benjamin Boucherle, Aurélien Rey, Maxime Rome, Nicola Fuzzati, Marine Peuchmaur. Development of an innovative maceration technique to optimize extraction and phase partition of natural products Fitoterapia, 2021;148,104798. https://doi.org/10.1016/j.fitote.2020.104798
CrossRef - Foss K, Przybyłowicz KE, Sawicki T. Antioxidant Activity and Profile of Phenolic Compounds in Selected Herbal Plants. Plant Foods Hum Nutr. 2022;77(3):383-389. doi:10.1007/s11130-022-00989-w
CrossRef - Matić P, Sabljić M, Jakobek L. Validation of Spectrophotometric Methods for the Determination of Total Polyphenol and Total Flavonoid Content. J AOAC Int. 2017;100(6):1795-1803. doi:10.5740/jaoacint.17-0066
CrossRef - Albayrak S, Aksoy A. Comparative analysis of phenolic compositions and biological activities of three endemic Teucrium L. (Lamiaceae) species from Turkey. An Acad Bras Cienc. 2023;95(1):e20220184. doi:10.1590/0001-3765202320220184
CrossRef - Raal A, Orav A, Nesterovitsch J, Maidla K. Analysis of Carotenoids, Flavonoids and Essential Oil of Calendula officinalis Cultivars Growing in Estonia. Nat Prod Commun. 2016;11(8):1157-1160
CrossRef - Kurtulbaş Şahin E, Bilgin M, Şahin S. Recovery of anthocyanins from sour cherry (Prunus cerasus L.) peels via microwave assisted extraction: monitoring the storage stability. Prep Biochem Biotechnol. 2021;51(7):686-696. doi:10.1080/10826068.2020.1852418
CrossRef - Hroshovyi TA, Martsenyuk VP, Kucherenko LI, etc. Mathematical planning of experiments in scientific research in pharmacy [in Ukrainian]. Ternopil, Ukraine: Ukrmedknyga; 2008.
- Hroshovyi TA, Demchuk MB, Beley NM, Nayda YV, Pavliuk BV. Experimental design in research on the creation of tableted medicinal products [in Ukrainian]. Pharmaceutical Review. 2020;(2):101-110. doi:10.11603/2312-0967.2020.2.11204.
CrossRef - Fukleva LA, Saliy ОО, Bаulа ОP, Puchkan LO, Hrechana ОV. Methods of mathematical planning of the experiment and their use in the development of the composition of the ointment with essential oil Thymus vulgaris аor vaginal application [in Ukrainian]. News Pharm. 2024;107(1):74-79. doi:10.24959/nphj.24.130
CrossRef - Dedić A, Džudžević-Čančar H, Alispahić A, Jerković-Mujkić A. Antimicrobial assessment of Prunus spinosa fruit extracts. Kem Ind. 2025;74(7-8):281-286. doi:10.15255/KUI.2024.050
CrossRef - Pozzo L, Russo R, Frassinetti S, et al. Wild Italian Prunus spinosa fruit exerts in vitro antimicrobial activity and protects against in vitro and in vivo oxidative stress. Foods. 2020;9(1):5. doi:10.3390/foods9010005
CrossRef - Tegos GP, Haynes M, Strouse JJ, et al. Microbial efflux pump inhibition: tactics and strategies. Curr Pharm Des. 2011;17(13):1291-302. doi:10.2174/138161211795703726
CrossRef - Engels C, Schieber A, Gänzle MG. Inhibitory spectra and modes of antimicrobial action of gallotannins from mango kernels (Mangifera indica). Appl Environ Microbiol. 2011;77(7):2215-2223. doi:10.1128/AEM.02521-10
CrossRef - Sallustio V, Marto J, Gonçalves LM, et al. Influence of Various Fruit Preservation Methods on the Phenolic Composition and Antioxidant Activity of Prunus spinosa Fruit Extract. Plants (Basel). 2025;14(15):2454. Published 2025 Aug 7. doi:10.3390/plants14152454
CrossRef - Veličković JM, Kostić DA, Stojanović GS, et al. Phenolic composition, antioxidant and antimicrobial activity of the extracts from Prunus spinosa fruit. Hem. Ind. 2014;68:297–303. DOI:10.2298/HEMIND130312054V
CrossRef - Taras V. Upyr, Larysa V. Lenchyk, Mykola А. Komisarenko, Ganjina F. Navruzzoda, Andriy M. Komisarenko, Tetiana P. Osolodchenko, Svitlana V. Ponomarenko. Study of Phenolic Compounds of Prunus Domestica Presscake and Antimicrobial Activity of Its Extract. Research Journal of Pharmacy and Technology. 2022; 15(1):375-0. doi: 10.52711/0974-360X.2022.00061
CrossRef - Magiera A, Czerwińska ME, Owczarek A, Marchelak A, Granica S, Olszewska MA. Polyphenol-Enriched Extracts of Prunus spinosaFruits: Anti-Inflammatory and Antioxidant Effects in Human Immune Cells Ex Vivo in Relation to Phytochemical Profile. Molecules. 2022;27(5):1691. doi:10.3390/molecules27051691
CrossRef - Martina Š, Molitorisová M, Mažerik J, Uhliariková I, Capek P. Pharmacological Effect of Water-Extractable (Poly)Phenolic Polysaccharide-Protein Complexes from Prunus spinosa Wild Fruits. Int J Mol Sci. 2025;26(13):5993. Published 2025 Jun 22. doi:10.3390/ijms26135993
CrossRef - Drăghici-Popa AM, Pârvulescu OC, Stan R, Brezoiu AM. Optimization of Ultrasound-Assisted Extraction of Phenolic Compounds from Romanian Blackthorn (Prunus spinosa) Fruits. Antioxidants (Basel). 2025;14(6):680. Published 2025 Jun 3. doi:10.3390/antiox14060680
CrossRef